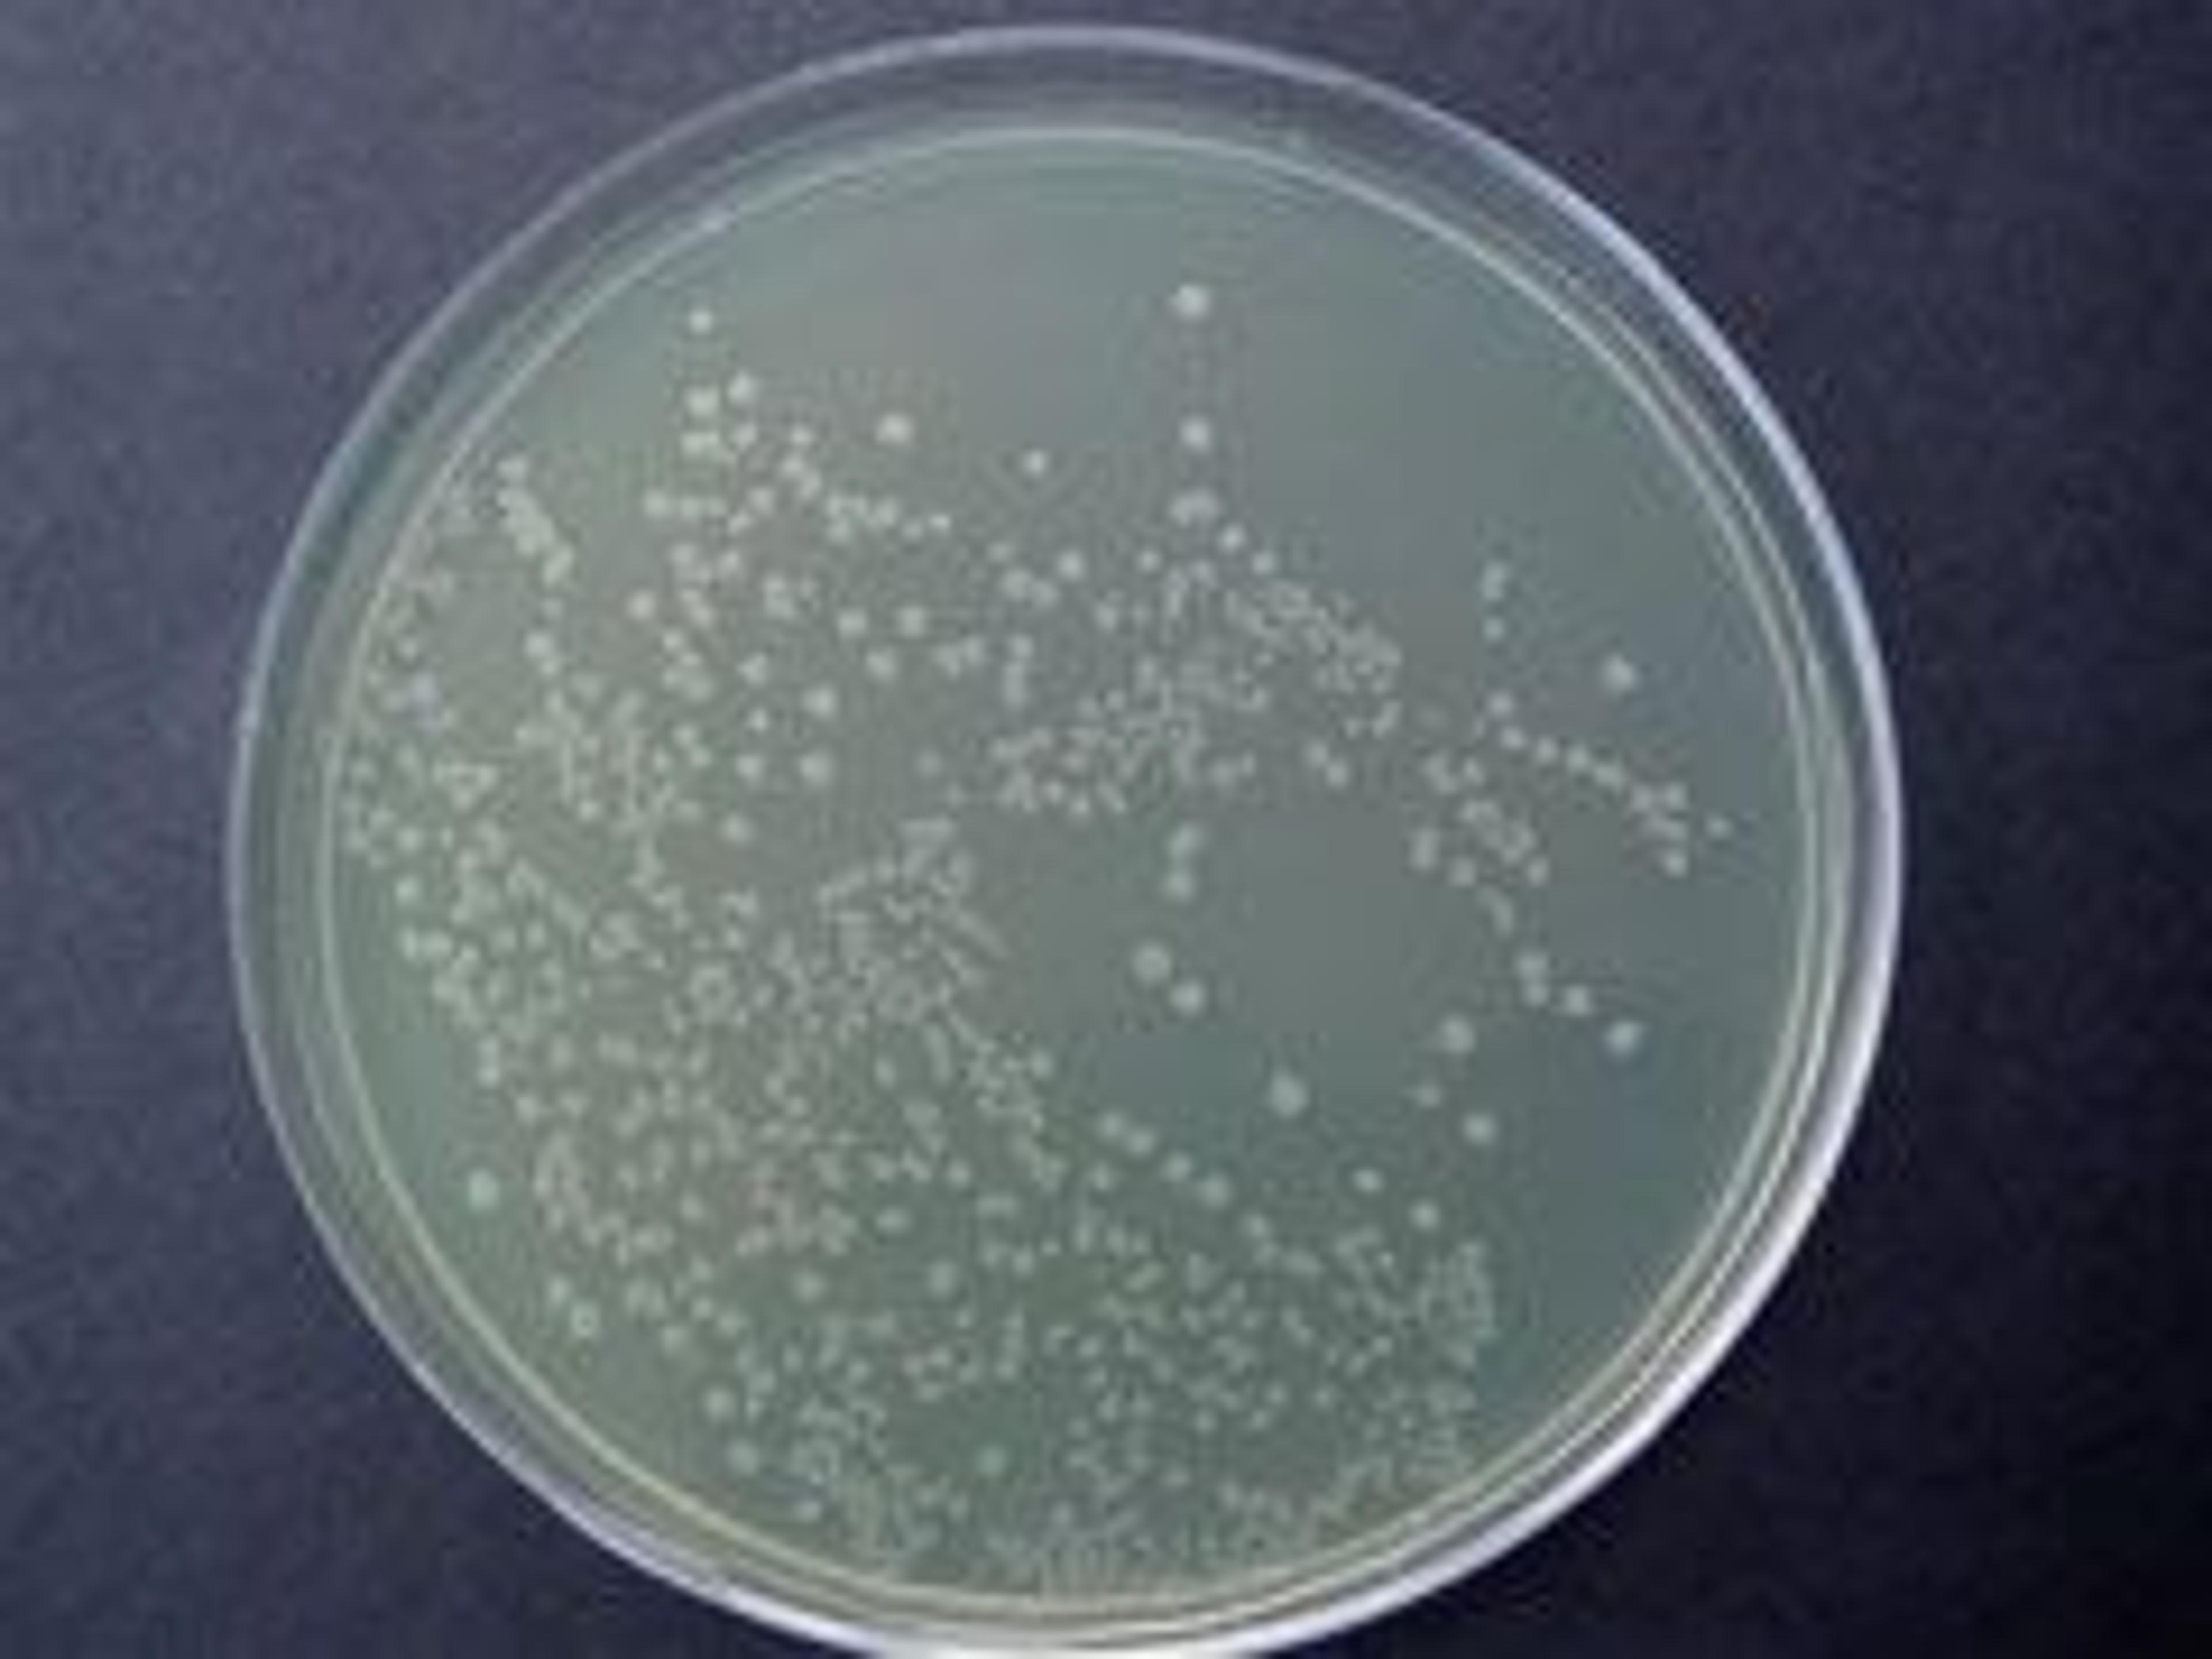
Smart Ampicillin™ - Axygen Scientific, Inc. - Life Sciences

Corning® 1700cm² Expanded Surface Polystyrene Roller Bottle with Easy Grip Cap, 5 per Bag, 40 per Case
Corning Life SciencesRibbed design provides twice the surface area with the same exterior dimensions. Bottles are manufactured from virgin polystyrene, caps from high density polyethylene Both resins meet the USP Class VI requirements for plastic containers and closures Treated for optimal cell attachment One piece seamless construction with printed graduations Printed lot numbers to aid in product traceability Sterilized by gamma radiatio…